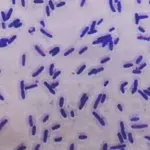
Energia rinnovabile dai batteri

Redazione
Articoli di Redazione

Clean Renewable Energy: ecco l'Abito Anticrisi
05 mar 2012

Legno a salvaguardia dell'ambiente
01 mar 2012

Sostenibilità Ambientale: roba da donne
29 feb 2012
Energia rinnovabile dai batteri
28 feb 2012

Moda ed ecologia: ecco la scarpa ecocompatibile
27 feb 2012

Costi ambientali elevati: WWF lancia l'allarme
24 feb 2012


